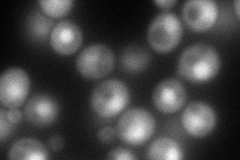
YHR121W
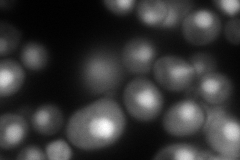
YHR121W
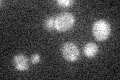
YHR121W

View description
Protein of unknown function that may function in RNA processing; interacts with Pbp1p and Pbp4p and associates with ribosomes; contains an RNA-binding LSM domain and an AD domain; GFP-fusion protein is induced by the DNA-damaging agent MMS
Localization:
Intensity:
Fold change:
Significance:
-
C’ GFP library in SD

cytosol36.08 -
N' NOP1pr-GFP in SD
cytosol,nucleus147.213 -
N' TEF2pr-mCherry in SD
nucleus205.561 -
N' NATIVEpr-GFP in SD

cytosol40.2963 -
N' TEF2pr-VC and Cyto-VN in SD

#N/A0 -
C’ GFP library in SD+DTT

cytosol29.550.81No -
C’ GFP library in SD+H2O2

cytosol27.220.75No -
C’ GFP library in Starvation Media
cytosol19.840.54No -
C’ GFP library on the background of Pup2-DaMP

cytosol -
C’ GFP library on the background of CCT mutant

cytosol33.12890.917983No
